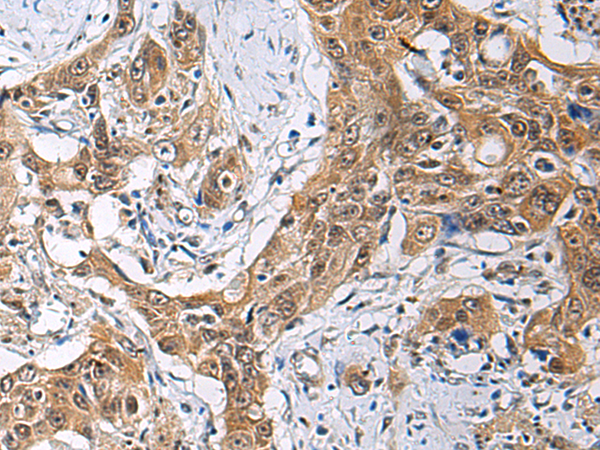
一抗

|
Background: |
This gene encodes a component of the nuclear THO transcription elongation complex, which is part of the larger transcription export (TREX) complex that couples messenger RNA processing and export. In humans, the transcription export complex is recruited to the 5'-end of messenger RNAs in a splicing- and cap-dependent manner. Studies of a related complex in mouse suggest that the metazoan transcription export complex is involved in cell differentiation and development. A pseudogene of this gene has been defined on chromosome 5. |
|
Applications: |
ELISA, WB, IHC |
|
Name of antibody: |
THOC3 |
|
Immunogen: |
Fusion protein of human THOC3 |
|
Full name: |
THO complex 3 |
|
Synonyms: |
THO3; hTREX45 |
|
SwissProt: |
Q96J01 |
|
ELISA Recommended dilution: |
5000-10000 |
|
IHC positive control: |
Human esophagus cancer |
|
IHC Recommend dilution: |
50-200 |
|
WB Predicted band size: |
39 kDa |
|
WB Positive control: |
Jurkat and PC3 cell lysates |
|
WB Recommended dilution: |
1000-5000 |


 購物車
購物車 幫助
幫助
 021-54845833/15800441009
021-54845833/15800441009